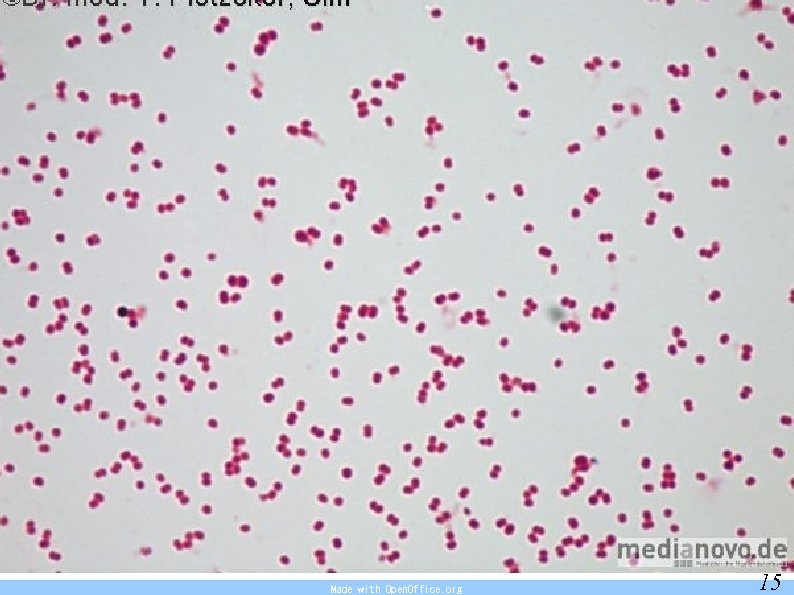
Made with Open. Office. org 15

3a2df8582a73fee7ea79f767cfc5266b.ppt
- Количество слайдов: 40
 Consciousness disorders, convulsive states Made with Open. Office. org 1
Consciousness disorders, convulsive states Made with Open. Office. org 1
 Consciousness Active state of human psyche, expresses relationship between one’s own personality and surrounding world. Alertness (vigilance), abstraction, verbalization, evaluation, self-consciousness (orientation in time, space, one’s own personality). Most sensitive indicator of state of human brain (and its blood circulation). Made with Open. Office. org 2
Consciousness Active state of human psyche, expresses relationship between one’s own personality and surrounding world. Alertness (vigilance), abstraction, verbalization, evaluation, self-consciousness (orientation in time, space, one’s own personality). Most sensitive indicator of state of human brain (and its blood circulation). Made with Open. Office. org 2
 Orientation examination of consciousness spontaneously conscious reaction to being addressed reaction to touch reaction to painful stimulus no reaction = opening of eyes; speaking; movement - flexion, extension, shivering (reaction of pupils to light, position + movement of eyeballs) Made with Open. Office. org 3
Orientation examination of consciousness spontaneously conscious reaction to being addressed reaction to touch reaction to painful stimulus no reaction = opening of eyes; speaking; movement - flexion, extension, shivering (reaction of pupils to light, position + movement of eyeballs) Made with Open. Office. org 3
 Changes in quality of consciousness Changed conscious content (confusedness, stupefied consciousness) The affected is disoriented; restless | anxious | puzzled. Speaks discontinuously, without succession and meaning, asks repeatedly the same. FA: !! be calm, do not let the affected get hurt or endanger the surroundings!! Made with Open. Office. org 4
Changes in quality of consciousness Changed conscious content (confusedness, stupefied consciousness) The affected is disoriented; restless | anxious | puzzled. Speaks discontinuously, without succession and meaning, asks repeatedly the same. FA: !! be calm, do not let the affected get hurt or endanger the surroundings!! Made with Open. Office. org 4
 Changes in quantity of consciousness somnolence = as if sleeping, does not speak spontaneously, but is able to wake up by being addressed or touched, fully oriented, but without external stimuli falls asleep again sopor = does not react to common stimuli, able to be brought to partial consciousness by a short-term strong = painful stimulus (without verbal reaction, only hand movement or blinking) coma = deep unconsciousness = the affected cannot be woken up by either sound or a painful stimulus, passive position, slowed breathing, sunken tongue, body is lifeless, threat of inhaling content of stomach. . . 0 reaction of pupils to light speed of change in consciousness – the faster the more serious Made with Open. Office. org 5
Changes in quantity of consciousness somnolence = as if sleeping, does not speak spontaneously, but is able to wake up by being addressed or touched, fully oriented, but without external stimuli falls asleep again sopor = does not react to common stimuli, able to be brought to partial consciousness by a short-term strong = painful stimulus (without verbal reaction, only hand movement or blinking) coma = deep unconsciousness = the affected cannot be woken up by either sound or a painful stimulus, passive position, slowed breathing, sunken tongue, body is lifeless, threat of inhaling content of stomach. . . 0 reaction of pupils to light speed of change in consciousness – the faster the more serious Made with Open. Office. org 5
 Glasgow coma scale 3 coma 15 points sopor somnolence consciousness Reaction eyes opening: verbal: 6 5 4 3 2 1 motoric: complies with an appeal oriented targeted reaction to pain spontaneous confused non-targeted reaction to pain to being addressed inadequate flexion to pain intelligible extension does not open eyes no no reaction Made with Open. Office. org 6
Glasgow coma scale 3 coma 15 points sopor somnolence consciousness Reaction eyes opening: verbal: 6 5 4 3 2 1 motoric: complies with an appeal oriented targeted reaction to pain spontaneous confused non-targeted reaction to pain to being addressed inadequate flexion to pain intelligible extension does not open eyes no no reaction Made with Open. Office. org 6
 Focal neurological symptoms: locomotion and perception disorder eye symptoms anisocoria (different width of pupils) maximum widening = mydriasis = insufficient blood circulation in brain maximum narrowing of pupils = miosis = intoxication with opiates photoreaction disorder = reaction of pupils to light crossing of eyeballs (squinting), spont. movements Made with Open. Office. org 7
Focal neurological symptoms: locomotion and perception disorder eye symptoms anisocoria (different width of pupils) maximum widening = mydriasis = insufficient blood circulation in brain maximum narrowing of pupils = miosis = intoxication with opiates photoreaction disorder = reaction of pupils to light crossing of eyeballs (squinting), spont. movements Made with Open. Office. org 7
 Causes of consciousness disorders: blood circulation disorder (shock) worsening of brain oxygenation (suffocation, CO intoxication) brain injury (head injury, cranial fractures) increase in intracranial pressure (tumour, cerebrovascular accident) intoxication disorder of internal environment (hypo-/hyperglycaemia) infection epilepsy injury by electricity Made with Open. Office. org 8
Causes of consciousness disorders: blood circulation disorder (shock) worsening of brain oxygenation (suffocation, CO intoxication) brain injury (head injury, cranial fractures) increase in intracranial pressure (tumour, cerebrovascular accident) intoxication disorder of internal environment (hypo-/hyperglycaemia) infection epilepsy injury by electricity Made with Open. Office. org 8
 FA: 1. basic life functions (ABC = foreign bodies, tongue, . . . ) 1. 2. if resuscitation is not needed – further examination – look for signs of head, neck, chest, abdomen or limb injuries 3. if spine is not injured – stabilised position and breath and pulse monitoring. 4. nothing per os, look for medicaments, ID for the diabetic, medical report, doctor’s certificate 5. transport by EA Made with Open. Office. org 9
FA: 1. basic life functions (ABC = foreign bodies, tongue, . . . ) 1. 2. if resuscitation is not needed – further examination – look for signs of head, neck, chest, abdomen or limb injuries 3. if spine is not injured – stabilised position and breath and pulse monitoring. 4. nothing per os, look for medicaments, ID for the diabetic, medical report, doctor’s certificate 5. transport by EA Made with Open. Office. org 9
 Non-traumatic causes of unconsciousness: Cerebrovascular accidents (CVA) Brain inflammation = infection. . . Collapse, faintness Made with Open. Office. org 10
Non-traumatic causes of unconsciousness: Cerebrovascular accidents (CVA) Brain inflammation = infection. . . Collapse, faintness Made with Open. Office. org 10
 CVA Bleeding – from split blood vessel to cerebral tissue – in place of haematoma loss of function sudden loss of function (from 50 years), meningeal symptoms, often high blood pressure Ischemic – resulting from insufficient blood circulation (blood clots, decrease of blood pressure) typical mild consciousness disorder – only dizziness, nausea function: focal neurological symptoms meningeal stimulation does not occur Embolism accidents embolus to great blood circulation – head – partial obstruction of arteries * for cardiac rhythm disorders Made with Open. Office. org 11
CVA Bleeding – from split blood vessel to cerebral tissue – in place of haematoma loss of function sudden loss of function (from 50 years), meningeal symptoms, often high blood pressure Ischemic – resulting from insufficient blood circulation (blood clots, decrease of blood pressure) typical mild consciousness disorder – only dizziness, nausea function: focal neurological symptoms meningeal stimulation does not occur Embolism accidents embolus to great blood circulation – head – partial obstruction of arteries * for cardiac rhythm disorders Made with Open. Office. org 11
 ischemia bleeding Made with Open. Office. org 12
ischemia bleeding Made with Open. Office. org 12
 CVA symptoms: Locomotion and perception disorder (face asymmetry, droopy corner) Eye symptoms Anisocoria (pupils differently wide) mydriasis, miosis Photoreaction disorder Eyeballs shift Loss of vision Nausea, vomiting, loss of balance Increase in pressure, slowed pulse Made with Open. Office. org 13
CVA symptoms: Locomotion and perception disorder (face asymmetry, droopy corner) Eye symptoms Anisocoria (pupils differently wide) mydriasis, miosis Photoreaction disorder Eyeballs shift Loss of vision Nausea, vomiting, loss of balance Increase in pressure, slowed pulse Made with Open. Office. org 13
 FA for CVA: vital functions transport – ambulance – hospital ABC CT thrombolytics up to 3 h from the beginnig Made with Open. Office. org 14
FA for CVA: vital functions transport – ambulance – hospital ABC CT thrombolytics up to 3 h from the beginnig Made with Open. Office. org 14
Made with Open. Office. org 15
Made with Open. Office. org 15
 Meningococcus Made with Open. Office. org 16
Meningococcus Made with Open. Office. org 16
 Inflammation of brain, meninges Encephalitis, meningitis Causes: bacteria (Neisseria meningitidis = meningococcus) viruses (herpetic virus = herpes) parasites Made with Open. Office. org 17
Inflammation of brain, meninges Encephalitis, meningitis Causes: bacteria (Neisseria meningitidis = meningococcus) viruses (herpetic virus = herpes) parasites Made with Open. Office. org 17
 Symptoms of meningitis: Made with Open. Office. org 18
Symptoms of meningitis: Made with Open. Office. org 18
 Encephalitis, meningitis – symptoms: fever, breathlessness, meningeal symptoms headache, sickness, vomiting, dizziness head bent backward, stiff neck muscles, flexion of limbs, photophobia, hyperhearing Made with Open. Office. org 19
Encephalitis, meningitis – symptoms: fever, breathlessness, meningeal symptoms headache, sickness, vomiting, dizziness head bent backward, stiff neck muscles, flexion of limbs, photophobia, hyperhearing Made with Open. Office. org 19
 FA: ABC temperature regulation, liquids (+paracetamol)– if conscious quiet medical examination (emergency) hospitalisation Mening. irritation present = high probability of meningitis Made with Open. Office. org 20
FA: ABC temperature regulation, liquids (+paracetamol)– if conscious quiet medical examination (emergency) hospitalisation Mening. irritation present = high probability of meningitis Made with Open. Office. org 20
 Meningococcal sepsis: Petechia: Do not waste time = call ambulance (high mortality within 24 h in spite of treatment) Penicillin administered in time can save life. Made with Open. Office. org 21
Meningococcal sepsis: Petechia: Do not waste time = call ambulance (high mortality within 24 h in spite of treatment) Penicillin administered in time can save life. Made with Open. Office. org 21
 line up Made with Open. Office. org 22
line up Made with Open. Office. org 22
 Faintness, collapse Short-term unconsciousness caused by short-term insufficient blood circulation in brain. Caused by (failure of circulation regulation = hypo-tension) : exhaustion, heat, long standing, hot space pain, psyche sudden change of position – quick standing up Made with Open. Office. org 23
Faintness, collapse Short-term unconsciousness caused by short-term insufficient blood circulation in brain. Caused by (failure of circulation regulation = hypo-tension) : exhaustion, heat, long standing, hot space pain, psyche sudden change of position – quick standing up Made with Open. Office. org 23
 Symptoms of faintness: being pale, sickness, sweating, low blood pressure loss of hearing, vision, loss of consciousness, fall Short-term unconsciousness bradycardia, palpable pulse Made with Open. Office. org 24
Symptoms of faintness: being pale, sickness, sweating, low blood pressure loss of hearing, vision, loss of consciousness, fall Short-term unconsciousness bradycardia, palpable pulse Made with Open. Office. org 24
 FA for faintness: leave lying on the floor, raise legs = autotransfusion position (better return of blood to heart – recovery of blood circulation in brain = recovery of consciousness) if recovery of consciousness is fast, colour returns, cause of faintness is known – doctor is not necessary while unconscious, ABC if longer than 1 min – ambulance (not a case of faintness) epileptic fit, arrhythmia – doctor Made with Open. Office. org 25
FA for faintness: leave lying on the floor, raise legs = autotransfusion position (better return of blood to heart – recovery of blood circulation in brain = recovery of consciousness) if recovery of consciousness is fast, colour returns, cause of faintness is known – doctor is not necessary while unconscious, ABC if longer than 1 min – ambulance (not a case of faintness) epileptic fit, arrhythmia – doctor Made with Open. Office. org 25
 Convulsive states Made with Open. Office. org 26
Convulsive states Made with Open. Office. org 26
 Convulsive states convulsion = involuntary contraction of striated muscles occurrence: ● at least 1 x in lifetime in as much as 10% of population maximum: ● children 1/2 year to 3 -4 years … puberty… + ● Made with Open. Office. org 27
Convulsive states convulsion = involuntary contraction of striated muscles occurrence: ● at least 1 x in lifetime in as much as 10% of population maximum: ● children 1/2 year to 3 -4 years … puberty… + ● Made with Open. Office. org 27
 Convulsions – classification: with consciousness disorder: febrile convulsions in children, epilepsy, eclampsia without consciousness disorder: tetanus, tetany Types of convulsion: Tonic – overall body stiffness, arched bent of torso, patient stops breathing (cyanosis) = muscle flexes and keeps tense Clonic – repeated muscle twitches = alternating tension and relaxation Made with Open. Office. org 28
Convulsions – classification: with consciousness disorder: febrile convulsions in children, epilepsy, eclampsia without consciousness disorder: tetanus, tetany Types of convulsion: Tonic – overall body stiffness, arched bent of torso, patient stops breathing (cyanosis) = muscle flexes and keeps tense Clonic – repeated muscle twitches = alternating tension and relaxation Made with Open. Office. org 28
 Causes of convulsions: high temperature – febrile convulsions meningocephalitis, brain inflammation epilepsy metabolical changes (Ca++, hypoglycaemia) cerebrovascular accidents, intracranial bleeding tumorous illnesses poisonings eclampsia – (formerly EPH gestosis) Made with Open. Office. org 29
Causes of convulsions: high temperature – febrile convulsions meningocephalitis, brain inflammation epilepsy metabolical changes (Ca++, hypoglycaemia) cerebrovascular accidents, intracranial bleeding tumorous illnesses poisonings eclampsia – (formerly EPH gestosis) Made with Open. Office. org 29
 FA for convulsions: Prevent secondary injury – fall, injury with surrounding objects Monitor duration of convulsions, unconsciousness During and after fit – ABC, stabilised position, limit commotion around = limit stimuli that could cause other convulsions Ambulance: breathing disorders, consciousness disorders, high fever, diabetes, little children, pregnant, first occurrence medical treatment: ordinary EPI fit in a known epileptic Made with Open. Office. org 30
FA for convulsions: Prevent secondary injury – fall, injury with surrounding objects Monitor duration of convulsions, unconsciousness During and after fit – ABC, stabilised position, limit commotion around = limit stimuli that could cause other convulsions Ambulance: breathing disorders, consciousness disorders, high fever, diabetes, little children, pregnant, first occurrence medical treatment: ordinary EPI fit in a known epileptic Made with Open. Office. org 30
 Made with Open. Office. org 31
Made with Open. Office. org 31
 Emergence of convulsions in Epilepsy epileptic focus = cells with pathological electrical activity low spread threshold epileptic impulse = photostimulation (cinema, fire), hyperventilation, rhythmical sounds (on a train, music – drums) Made with Open. Office. org 32
Emergence of convulsions in Epilepsy epileptic focus = cells with pathological electrical activity low spread threshold epileptic impulse = photostimulation (cinema, fire), hyperventilation, rhythmical sounds (on a train, music – drums) Made with Open. Office. org 32
 Epilepsy E. stimulus (rhythmical sound, colours, cinema, television) Brain reaction: ● ● ● sensory symptoms (visual, auditory, olfactory perception) fit of convulsions, consciousness disorder Typical Grand. Mall: Aura, Cry, Fall, Fit Tonic, Clonic, Urine, Sh-- (sleep) Other manifestations: Absence = eyes fixed, eyes turned up Convulsions localised at 1 limb, muscle group Made with Open. Office. org 33
Epilepsy E. stimulus (rhythmical sound, colours, cinema, television) Brain reaction: ● ● ● sensory symptoms (visual, auditory, olfactory perception) fit of convulsions, consciousness disorder Typical Grand. Mall: Aura, Cry, Fall, Fit Tonic, Clonic, Urine, Sh-- (sleep) Other manifestations: Absence = eyes fixed, eyes turned up Convulsions localised at 1 limb, muscle group Made with Open. Office. org 33
 Epilepsy FA Call ambulance: first time in life diabetes child disorder of breathing Status Epilepticus = A prolonged seizure (usually defined as lasting longer than 30 minutes) or a series of repeated seizures; a continuous state of seizure activity. Not necessary call ambulance epi. patient – care about ABC, . . . Made with Open. Office. org 34
Epilepsy FA Call ambulance: first time in life diabetes child disorder of breathing Status Epilepticus = A prolonged seizure (usually defined as lasting longer than 30 minutes) or a series of repeated seizures; a continuous state of seizure activity. Not necessary call ambulance epi. patient – care about ABC, . . . Made with Open. Office. org 34
 Febrile convulsions Convulsions + consciousness disorder, children (6 M. . 6 L) with fever (over 39°C), tachycardia, sweating. FA: cooling: remove blanket, wrap, if conscious – enough liquids, Paralen (painkiller). During a fit of convulsions, unconsciousness (10 min) – Ensure clear airways. Do not prevent child from movements during convulsions. Do not put anything into mouth during convulsions (inhaling). Medical examination Made with Open. Office. org 35
Febrile convulsions Convulsions + consciousness disorder, children (6 M. . 6 L) with fever (over 39°C), tachycardia, sweating. FA: cooling: remove blanket, wrap, if conscious – enough liquids, Paralen (painkiller). During a fit of convulsions, unconsciousness (10 min) – Ensure clear airways. Do not prevent child from movements during convulsions. Do not put anything into mouth during convulsions (inhaling). Medical examination Made with Open. Office. org 35
 Eclampsia = advanced stadium of EPH gestosis (oedemas, proteinuria, hypertension), illness is related to pregnancy (placenta), oedema of brain, lungs – disorder of consciousness, convulsions, insufficient breathing, low blood pressure, shock FA: ambulance, hospitalisation, termination of pregnancy Made with Open. Office. org 36
Eclampsia = advanced stadium of EPH gestosis (oedemas, proteinuria, hypertension), illness is related to pregnancy (placenta), oedema of brain, lungs – disorder of consciousness, convulsions, insufficient breathing, low blood pressure, shock FA: ambulance, hospitalisation, termination of pregnancy Made with Open. Office. org 36
 Tetany = increased readiness for convulsions (tonic). occurs during lower concentration of Ca++ in blood: changes of internal environment = alkalosis - hyperventilation after psychical stress; (hysteria) - after repeated vomiting FA: calm patient down, sit in half-upright position hyperventilation tetany – plastic/paper bag, reinhalation of CO 2 Doctor – Calcium i. v. Made with Open. Office. org 37
Tetany = increased readiness for convulsions (tonic). occurs during lower concentration of Ca++ in blood: changes of internal environment = alkalosis - hyperventilation after psychical stress; (hysteria) - after repeated vomiting FA: calm patient down, sit in half-upright position hyperventilation tetany – plastic/paper bag, reinhalation of CO 2 Doctor – Calcium i. v. Made with Open. Office. org 37
 Tetanus infection with Clostridium tetani = spores in soil --> wound --> toxin production (days) – block of neuromuscular transfer: difficulties chewing, trismus = flexed chewing muscles, generalisation of convulsions paralysis –> suffocating while fully conscious Prevention: vaccination (re-vaccination á 10 y) Prevention: treatment of wound with H 2 O 2 FA&Th: artificial respiration Made with Open. Office. org 38
Tetanus infection with Clostridium tetani = spores in soil --> wound --> toxin production (days) – block of neuromuscular transfer: difficulties chewing, trismus = flexed chewing muscles, generalisation of convulsions paralysis –> suffocating while fully conscious Prevention: vaccination (re-vaccination á 10 y) Prevention: treatment of wound with H 2 O 2 FA&Th: artificial respiration Made with Open. Office. org 38
 Botulinism ingestion of contaminated food – Clostridium botulinum (home made canned food) – botulotoxin double vision, unclear speaking, difficulties chewing, swallowing muscular weakness, considerable muscular weakness, palsy without convulsions and while fully conscious FA: doctor – UPV, administration of antitoxin Made with Open. Office. org 39
Botulinism ingestion of contaminated food – Clostridium botulinum (home made canned food) – botulotoxin double vision, unclear speaking, difficulties chewing, swallowing muscular weakness, considerable muscular weakness, palsy without convulsions and while fully conscious FA: doctor – UPV, administration of antitoxin Made with Open. Office. org 39
 Summary: DR ABC (shake, shout) what’s your name where are you what’s the day today Do you have some pain? Can you move? open, close eyes whistle extremities Made with Open. Office. org 40
Summary: DR ABC (shake, shout) what’s your name where are you what’s the day today Do you have some pain? Can you move? open, close eyes whistle extremities Made with Open. Office. org 40


